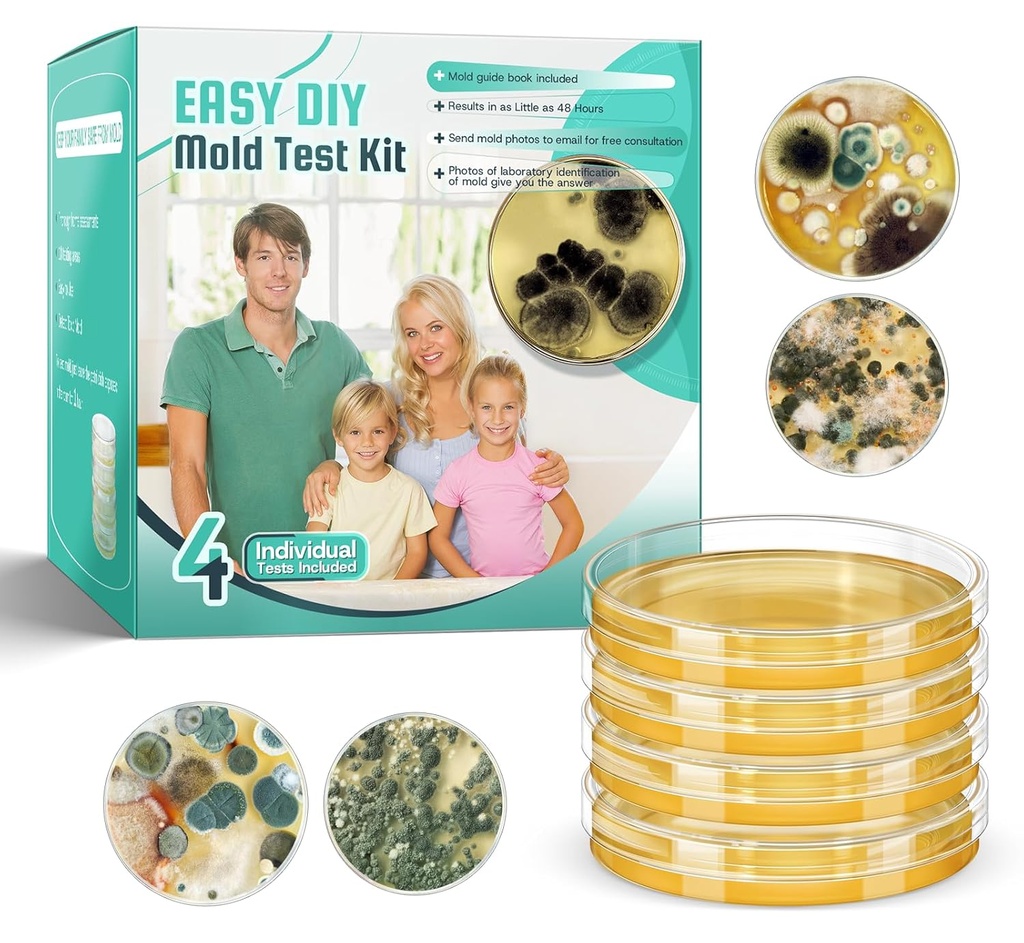
Mold Test Kit for Home Detection: 4 Simple DIY Science Kits for Fastly Testing Home Surfaces & Air Quality Detector & HVAC Monitor Includes Detailed Identification Guide

Mold Test Kit for Home Detection: 4 Simple DIY Science Kits for Fastly Testing Home Surfaces & Air Quality Detector & HVAC Monitor Includes Detailed Identification Guide
- 4 COMPREHENSIVE TESTS FOR A HEALTHY HOME: This home mold test kit tests HVAC systems, home surfaces, and indoor air quality, providing a comprehensive view of your home environment and ensuring your family's health
- DIY MOLD Detection, EASY TO USE: This DIY scientific test kit includes professional mold testing tools and related accessories needed as well as a detailed mold identification guide. No expertise needed—easily detect potential issues at home
- FAST & RELIABLE MOLD DETECTOR: This mold testing kit for home includes a mold identification guide that provides fast and reliable results. You can easily identify and understand the type of mold present in your home, enabling prompt and effective action
- SUITABLE FOR MULTIPLE SCENARIOS: This mold detection test is ideal for homes, offices, schools and more. Great for renters, homeowners and property managers
- COST EFFECTIVE AND PROFESSIONAL RESULTS: This home mold test not only gives you accurate results at an affordable price, convenient for DIY.
-
Save 10% when you buy two or more items.
-
Get 5% off your next purchase.
-
Enjoy free delivery on orders above $200.
-
Orders are processed and shipped from Canberra
Estimate delivery times: 12-26 days (International).
3-6 days (Domestic)
3-6 days (Domestic)
Guaranteed Safe Checkout
30-Day Return Guarantee
Confidence-backed purchases with 30-day return support.
Confidence-backed purchases with 30-day return support.
Free return pickup available
We’ll handle returns from your doorstep at no extra cost.
AUD |
BRSREY3ROIHQOHY3 |
Product Dimensions
4 x 4 x 4 inches; 7.58 ounces
| Brand | Right Coast |
Shipping & Delivery
At GofinchKart Australia, we aim to deliver your order quickly and safely.
Domestic Shipping (Australia):
Orders are typically delivered within 3–7 business days.
International Shipping:
Estimated delivery time is 12–26 business days, depending on the destination and customs processing.
Once your order has been dispatched, you will receive a tracking number. Delivery times may vary during public holidays or due to unforeseen delays.